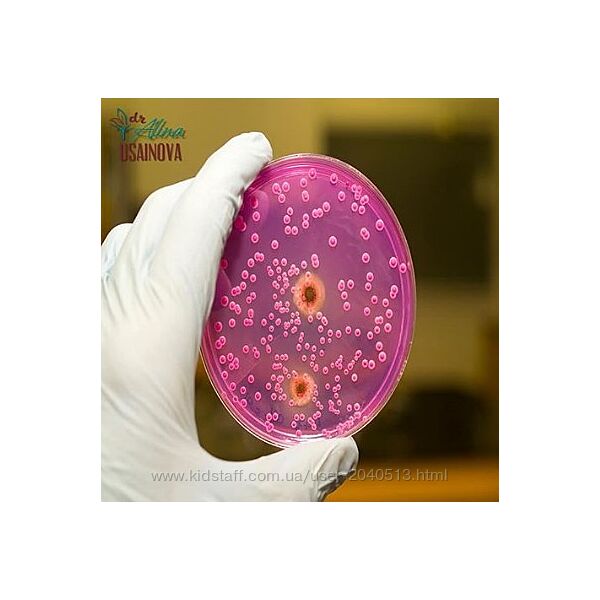
Алина Усаинова - Хочу избавиться от кандидоза

300₴
Алина Усаинова - Хочу знать все про анемию
300₴
Характеристики товара:
| Состояние | Новое |
| Для | взрослых |
| Тематика | Здоровье |
| Вид | Курс, Лекции |
Доставка: в любую страну, указано в объявлении | Киев | Наложенного платежа нет | Возврат: не предусмотрен | Актуально на: 02 ноября 2025
Информация о продавце
Premium магазин
"Курсы для Развития"
Premium магазин
"Курсы для Развития"
Регистрация: 18.09.2021
Заходил(а): 04.11.2025 (00:33)
Заходил(а): 04.11.2025 (00:33)
Откуда: Украина, Киев
Разделы Premium магазина:
Кондитерка Психология Кулинария Любовь, Отношения, Секс Эзотерика Фото и видео Макияж, Визаж, Татуаж Таргетинг, SMM Дети и родители Иностранные языки Здоровье, спорт, питание Развитие, интеллект
Подробное описание: Алина Усаинова - Хочу знать все про анемию
ЧТОБЫ СДЕЛАТЬ ЗАКАЗ – ОТПРАВЬТЕ СООБЩЕНИЕ в Телеграм / Вайбер +380633727955При покупке двух курсов - третий курс в ПОДАРОК!
Не можете найти курс? Напишите и найдем под заказ
Добавьте объявление в избранное чтобы не потерять
Для Вас всегда новые курсы по самым низким ценам
Смотрите другие объявления
___________________________________________________________________________________________
• Алина Усаинова - Хочу знать все про анемию
___
Онлайн курс «Хочу знать всё про анемию»
Узнайте за 5 недель как преодолеть анемию при поддержке врача!
Этот курс нужен вам, если у вас:
Слабость, повышенная утомляемость
Снижение трудоспособности
Снижение умственной работоспособности, памяти
Недостаточная концентрация внимания
Дневная сонливость
Головные боли
Одышка и сердцебиение (ЧСС 75 уд/мин) при обычных нагрузках
Склонность к обморокам в душной обстановке
Снижение давленияМелькание «мушек» (потемнение) перед глазами
Шум в ушах
Трудности при проглатывании твердой пищи, таблеток, капсул
Снижение мышечного тонуса, мышечная слабость
Онемение пальцев рук и ног
Отвращение к некоторым продуктам питания (мясо/рыба/яйца)
Тяга к непищевым веществам (глина/мел/тесто)Тяга к специфическим запахам (бензин/ацетон/лак/краски/табак)
Повышенная предрасположенность к инфекциям (ангина/тонзилит/молочница/герпес/фурункулез)
Обильные месячные (из-за снижения прогестерона при анемии)Сухость кожи, сухость локтей (из-за снижения функции щитовидной железы - гипотиреоза при анемии)
Ломкость и исчерченность ногтей
Трещины кожи пяток, пальцев
Голубоватый оттенок склер («белки» глаз)
Пониженный аппетит
Что вас ждет на курсе:
Более 20 часов концентрата только нужной информации
8 вебинаров про анемию
3 дополнительных бонусных вебинара
4 приглашенных эксперта
Индивидуальная работа с автором курса
Домашние задания
Контрольная заключительная встреча через пол года для отметки результатов. Схемы по профилактике и нормализации анемии
Режим питания, меню
Программа курса.
Программа рассчитана на 5 недель. Каждую неделю вам будут открываться доступ к двум вебинарам.
Время
Спикеры
Темы уроков и вебинаров
1я неделя Доктор Усаинова Лиана Ильфаровна
Кровь. Функция крови. Классификация анемий. Варианты гемоглобина. Что такое гем? Биосинтез и распад гема. Что такое глобин? Вред повышенного билирубина. Что делать? Виды желтухи.
Психолог Царева Кристина Алексеевна
Влияние психосоматики на анемию
2я неделя Доктор Усаинова Лиана Ильфаровна
Анемия. Стадии. Степени. Анемический синдром. Сидеропенический синдром. По каким клиническим признакам можно заподозрить анемию? Опасность анемии при беременности,у детей. Как читать анализы?
Косметолог Тукаева Алия Айрато
вна Взгляд практикующего косметолога на проблему кожи при анемии. Рекомендации по уходу для замедления старения
3я неделя Доктор Усаинова Лиана Ильфаровна
Как нормализовать поступление кислорода? Почему некоторым хорошо без мяса? Как улучшить выработку своей соляной кислоты? Железодефицитная анемия. Метаболизм железа. Гемовое и негемовое железо. Чем компенсировать дефицит? Легкоусвояемые формы железа. Как улучшить всасываемость и окисление железа? Почему быстро падает ферритин? При каких условиях можно в/в инъекции железа?
Доктор Усаинова Алина Ильфаровна Ускоренное окисление холестерина при анемии - причина бляшек на сосудах (атеросклероза)
4я неделя Доктор Усаинова Лиана Ильфаровна
Безопасный и самый необходимый антигипоксант! Что это? Почему одним железом анемию не вылечить? В12 дефицитная Анемия. Циркуляционно-гипоксический синдром. Гастроэнтерологический синдром. Синдром нейропсихический расстройств. Гематологический синдром. Можно ли быть веганом? Какие анализы информативнее?
Доктор Усаинова Лиана Ильфаровна
В9 дефицитная анемия. Повышение потребности в В9. Мутации в генах фолатного цикла. Чем компенсировать? Натуральные формы витаминов. Место хлорофилла в лечении анемий. Показания и противопоказания. Разбор питания.
5я неделя Доктор Усаинова Лиана Ильфаровна
Онлайн встречи с доктором в формате "вопросы-ответы"
___________________________________________________________________________________________
Гарантии. Ссылка на курс в облачном хранилище после оплаты
Не можете найти курс? Напишите и найдем под заказ